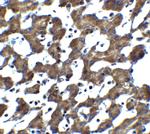
ST2 Antibody in Immunohistochemistry (IHC)

Search
Invitrogen
ST2 Polyclonal Antibody
{{$productOrderCtrl.translations['antibody.pdp.commerceCard.promotion.promotions']}}
{{$productOrderCtrl.translations['antibody.pdp.commerceCard.promotion.viewpromo']}}
{{$productOrderCtrl.translations['antibody.pdp.commerceCard.promotion.promocode']}}: {{promo.promoCode}} {{promo.promoTitle}} {{promo.promoDescription}}. {{$productOrderCtrl.translations['antibody.pdp.commerceCard.promotion.learnmore']}}
产品信息
PA5-20077
种属反应
已发表种属
宿主/亚型
分类
类型
抗原
偶联物
形式
浓度
规格
纯化类型
保存液
内含物
保存条件
运输条件
RRID
产品详细信息
The immunogenic sequence is common to all three known ST2 isoforms.
A suggested positive control is 293 cell lysate.
PA5-20077 can be used with blocking peptide PEP-0195.
靶标信息
IL-33R, also known as ST2, is a receptor for IL-33. It is a member of the IL-1 receptor family of innate receptors. Its extracellular domain consists of 3 Ig-like domains that directly interact with its co-receptor IL-1RAcP, and the ligand alarmin, IL-33. IL-33 ligation results in the association of IL-33R complex with its adaptor proteins MyD88, IRAK1, IRAK4 and TRAF6, and activation of the NF-kB, and MAPK pathways. This, in turn, instigates the release of chemokines and cytokines such as IL-5, IL-6, IL-8, and IL-13. Two most common isoforms of IL-33R that result from alternative splicing are ST2L - the membrane bound form, and ST2S - the soluble form. The membrane bound form can be released from the cell surface by proteolytic cleavage. The soluble forms have been suggested to act as decoys dampening the IL-33 signaling. IL-33R is primarily expressed by mast cells, basophils, and eosinophils. In mouse, IL-33R expression has been shown on ILC2 and Th2 cells. IL-33R signaling has been implicated in the number of immune conditions, including allergies, arthritis, atherosclerosis and sepsis.
仅用于科研。不用于诊断过程。未经明确授权不得转售。
生物信息学
蛋白别名: growth stimulation-expressed; homolog of mouse growth stimulation-expressed; IL-1 R4; IL-1RL1; IL-33R; interleukin 1 receptor-related protein; Interleukin-1 receptor-like 1; Interleukin-33 receptor alpha chain; Interleukin1 receptor like 1; Lymphocyte antigen 84; Protein ST2; Protein T1; sIL 33R; soluble IL 33 Receptor; soluble IL 33R; soluble protein receptor; unnamed protein product
基因别名: DER4; FIT-1; IL1RL1; IL33R; Ly84; ST2; St2-rs1; ST2L; ST2V; Ste2; T1; T1/ST2
UniProt ID: (Human) Q01638, (Mouse) P14719
Entrez Gene ID: (Human) 9173, (Mouse) 17082